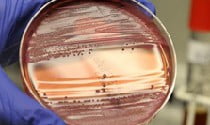

Энтеровирусная инфекция — группа инфекционных заболеваний, вызванных более 70 штаммами энтеровирусов.
Читать »Инфекционные заболевания
Инфекционные болезни -многочисленная группа заболеваний, объединяющая все воспалительные процессы, возникающие от проникновения в организм болезнетворных микроорганизмов.
Аспергиллез — что это такое и как лечить?
Аспергиллез — заболеваний грибковой этиологии, возбудителями которого являются плесневые грибки аспергиллы. Они могут поражать не только кожу, но и слизистые оболочки внутренних органов.
Читать »Трихинеллез: симптомы у человека, лечение и профилактика
Трихинеллез — крайне опасное паразитарное заболевание, острое течение которого может иметь тяжелые для больного последствия.
Читать »Дизентерия: симптомы, причины и лечение у взрослых
Дизентерией называется инфекционное поражение ЖКТ, источник которого локализуется преимущественно в толстой кишке.
Читать »Болезнь Лайма: симптомы, диагностика и лечение
Болезнью Лайма называется трансмиссивная патология, возбудителями которой являются болезнетворные бактерии рода Borrelia.
Читать »Как лечить Вирус Эпштейна-Барр и что это такое?
Вирус Эпштейна-Барр — одна из разновидной герпесвируса. Попадая в организм человека, ВГЧ 4 типа остается в нем навсегда. Но болезнь проявляется далеко не во всех случаях, поэтому человек, будучи его носителем, может даже не подозревать об этом.
Читать »Токсокароз у человека: первые симптомы и схема лечения
Токсокароз — разновидность гельминтоза, возбудителем которой является токсокар.
Читать »Эхинококкоз, что это такое? Причины и лечение у человека
Эхинококкоз — разновидность глистной инвазии, возбудителем которой являются эхинококки, относящиеся к группе ленточных червей (цестод).
Читать »Сальмонеллез, что это такое? Симптомы и схема лечения
Сальмонеллез является полиэтиологическим заболеванием, причиной развития которого становятся разные виды бактерий группы сальмонелл.
Читать »Энтеробиоз, что это такое? Симптомы, причины и лечение
Энтеробиоз — самая распространенная разновидность гельминтоза, подразумевающая поражение человеческого организма острицами.
Читать »Как вывести глистов с помощью чеснока? Рецепты и отзывы
Гельминтоз — это заболевание, которое поражает и детей, и взрослых. Несмотря на широкий ассортимент противоглистных лекарств, отпускающихся в аптеках без рецепта, многие люди отдают предпочтение старому и надежному средству — чесноку.
Читать »Стрептодермия — симптомы, причины и лечение
Стрептодермия у детей различного возраста развивается вследствие поражения различными штаммами распространенного микробного агента стрептококка и снижение эффективности иммунной защиты.
Читать »Дифтерия — что это такое? Фото, симптомы и лечение
Дифтерия — острое инфекционное заболевание, вызываемое бактериями дифтерии, передающееся преимущественно воздушно-капельным путем, характеризующееся воспалением, чаще всего слизистых оболочек рото- и носоглотки, а также явлениями общей интоксикации, поражением сердечно-сосудистой, нервной и выделительной систем.
Читать »Описторхоз у взрослых — симптомы, профилактика и лечение
С детства мы знаем, как вкусна и полезна рыба, вареная, жареная, запеченная в духовке. Нам говорят про фосфор, йод и омега-3, однако часто забывают сказать, что именно рыба может стать серьезной причиной возникновения не самого приятного заболевания, которое называется описторхоз.
Читать »Сепсис — что это такое? Причины, симптомы и лечение
Сепсис — это тяжелое инфекционное заболевание, развивающееся при прогрессировании и распространению инфекционного процесса по организму через кровь.
Читать »Бруцеллез у человека — симптомы, профилактика и лечение
Бруцеллёз (мальтийская лихорадка) — зоонозное инфекционное заболевание, вызываемое различными видами бруцелл.
Читать »Лямблии у взрослых — симптомы, диагностика и лечение
Лямблиоз — это распространенное инфекционное заболевание организма человека, вызванное кишечным одноклеточным паразитом лямблией. Встречается лямблиоз у взрослых и детей во всем мире.
Читать »Инфекционный мононуклеоз у детей — симптомы и лечение
Заболевание инфекционный мононуклеоз у детей называют железистой лихорадкой. Это вирусная болезнь, которая характеризуется длительным повышением температуры, ангиной, увеличением различных групп лимфоузлов, специфическими изменениями в периферической крови.
Читать »Полиомиелит — что это такое? Симптомы и лечение, прогноз
Полиомиелит — это острое вирусное заболевание, поражающее центральную нервную систему, в первую очередь спинной мозг, и иногда вызывающее паралич.
Читать »Аскаридоз у взрослых — симптомы и лечение, профилактика
Аскаридоз представляет собой возбуждаемое паразитами заболевание, которым страдают люди, в чьих организмах оказываются аскариды (глистные паразиты из группы нематодов).
Читать »Цитомегаловирус — симптомы, причины и лечение
Цитомегаловирус — это вирус, широко распространенный во всем мире среди взрослых и детей, относящийся к группе вирусов герпеса.
Читать »Клещевой энцефалит — симптомы, профилактика и лечение
Клещевой энцефалит — это острое вирусное заболевание, которое поражает в основном нервные клетки в организме человека. Это могут быть структуры головного мозга, периферическая иннервация или корешковые нервные окончания в спинном мозге.
Читать »Герпес на интимном месте — симптомы и лечение
Возникновение герпеса на губе знакомо многим, но вот что такое герпес в интимной зоне и почему он возникает, знают далеко не все люди.
Читать »Корь у детей — фото, симптомы и лечение, профилактика
Корь у детей — типичная вирусная инфекция, вызванная вирусом кори. Имеет специфические симптомы (сыпь), по которым заболевание легко выявить. Корь очень заразна, передаётся по воздуху. Инкубационный период длится до нескольких недель.
Читать »Корь у взрослых — симптомы и лечение
Корь — это острое вирусное заболевание, которое является одной из самых заразных и распространенных инфекций. Возбудитель кори — РНК-вирус рода морбилливирусов, который передается воздушно-капельным путем.
Читать »Ротавирусная инфекция у взрослых — симптомы и лечение
Ротавирусная инфекция определяется как ротавирус, кишечный грипп, ротавирусный гастроэнтерит.
Читать »Болезнь рожа на ноге — фото, симптомы и лечение
Рожа — болезнь инфекционного характера, вызываемая гемолитическими стрептококками. Воспаления и деформации затрагивают четко ограниченный участок кожного покрова, сопровождаются лихорадкой и интоксикацией организма.
Читать »Что такое реактивный менингит: симптомы и лечение
Реактивный менингит представляет собой наиболее опасную форму инфекционного заболевания, поражающего отделы спинного и головного мозга.
Читать »Туберкулез кожи — симптомы и лечение
Туберкулез кожи — это весьма обширная и разнообразная по своим проявлениям группа дерматозов, возникновение и развитие которых обусловлено проникновением в кожу и подкожную клетчатку туберкулезных микобактерий.
Читать »Краснуха у взрослых: фото, симптомы и лечение, профилактика
Краснуха относится к так называемым «детским» заболеваниям, которыми болеют преимущественно маленькое население планеты. Переболев в детстве, человек приобретает пожизненную сопротивляемость к этому заболеванию.
Читать »